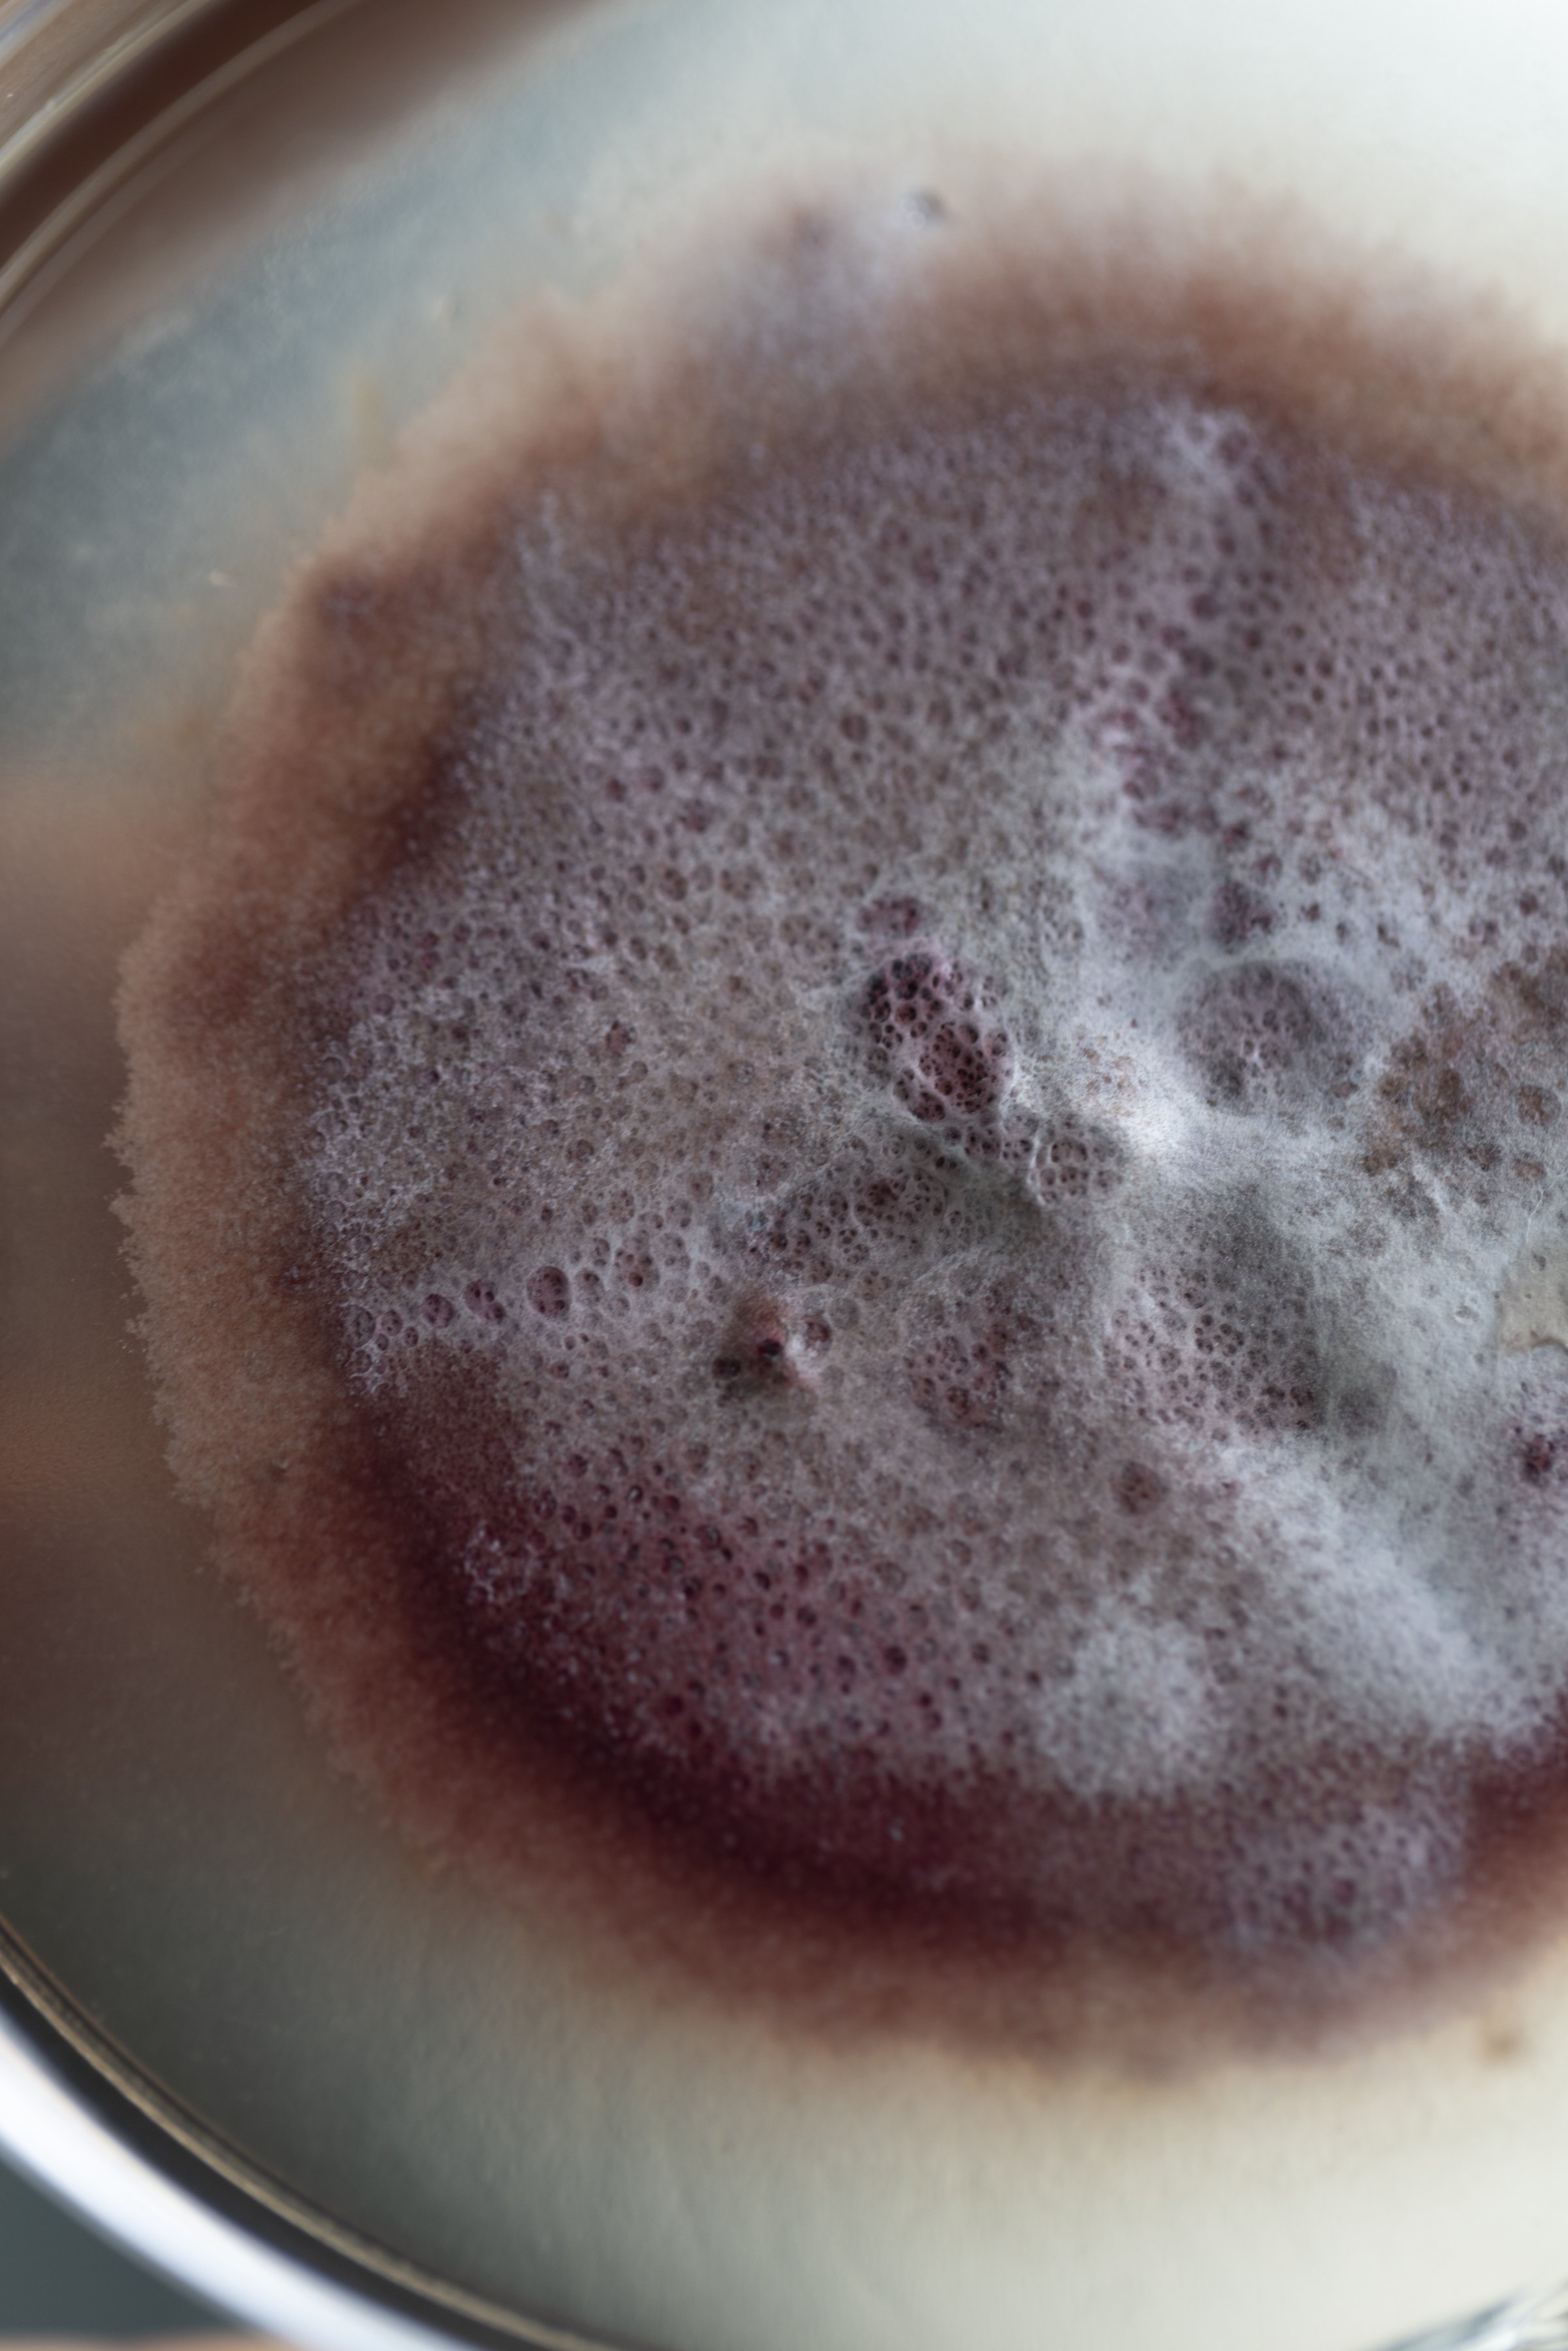
Close-up of mycelium growing inside Monterr Lab, showing its organic textures and fibrous structure.

GROWING THE FUTURE
AT MONTERR, WE CULTIVATE LIVING SYSTEMS — FUNGI & MYCELIUM — TO CREATE SUSTAINABLE BIOMATERIALS, COMPOSTABLE PACKAGING, AND MATERIALS FOR DESIGN AND ARCHITECTURE.
FUNGI
FUNGI
We are a design and research laboratory based in Mexico City, operating at the intersection of science, art, and sustainability.
Our mission: integrate living systems, fungi and biomaterials into design and medicine to cultivate a future where technology, ecology, and regenerative materials coexist in harmony.
Why Mycelium?
Strong & Lightweight
100% Compostable & Biodegradable
Regenerative Alternative to Plastics
Mycelial networks are nature’s most resilient and complex systems — lightweight, durable, and fully biodegradable.
At Monterr, we harness this living architecture to design sustainable, circular packaging and biomaterials that outperform conventional plastics.
MYCELIUM _THE ANCIENT SHAPING THE FUTURE
100% biodegradable
Mycelium-based materials are strong, lightweight, and fully compostable, offering a regenerative and intelligent alternative to plastic and styrofoam packaging in a world urgently seeking sustainable materials.
-

MONTERR PACK
Eco packaging solutions that replace traditional plastics and styrofoam.
Lightweight, compostable, and entirely grown — not built. -

MONTERR STUDIO
From interiors to installations, we apply mycelium-based biomaterials in architecture and objects that blur the line between biology and design.